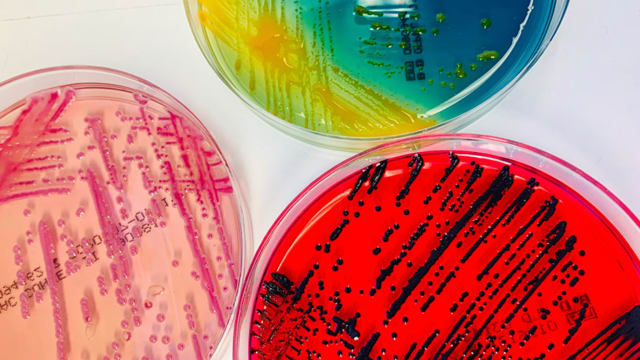
image

Forscher der Universität Basel und des Universitätsspitals Basel haben seit 2014 Patientenproben mit unbekannten Keimen systematisch gesammelt und untersucht. Wie das Team nun in «BMC Microbiology» berichtet, fanden sie mittlerweile über dreissig neue Bakterienarten.
Insgesamt nahm die Gruppe um den Mikrobiologen Daniel Goldenberger 61 unbekannte bakterielle Keime aus Blut- oder Gewebeproben auf. Das heisst: Die konventionellen Labormethoden hatten keinen Treffer geliefert. Und so sequenzierten die Wissenschaftler das gesamte Erbgut dieser Bakterien. Die ermittelten Genomsequenzen glichen sie dann – mithilfe eines Online-Tools – mit bereits bekannten Bakterienstämmen ab.
Resultat: 35 der 61 Bakterien waren bisher nicht bekannt; bei den restlichen Stämmen waren die Genomsequenzen erst seit Kurzem in Datenbanken abgelegt, oder diese Keime waren erst kürzlich korrekt taxonomisch beschrieben worden.
Sieben der 35 neuen Stämme erwiesen sich als klinisch relevant. Der grösste Teil der neu identifizierten Arten gehört zu den Gattungen Corynebacterium und Schaalia. «Viele Arten aus diesen beiden Gattungen finden sich im natürlichen menschlichen Mikrobiom der Haut und der Schleimhäute», sagt Daniel Goldenberger: «Sie werden deswegen häufig unterschätzt und sind wenig erforscht.»
Pseudoclavibacter triregionum
Klinisch bedeutsam könnte ein Keim sein, der aus dem entzündeten Daumen eines Patienten stammte, der von einem Hund gebissen worden war. Eine kanadische Forschungsgruppe hat dieses Bakterium kürzlich ebenfalls aus Wunden von Hunde- und Katzenbissen isoliert. «Wir nehmen deshalb an, dass es sich dabei um einen neu aufkommenden Krankheitserreger handelt, den wir im Auge behalten müssen», sagt Goldenberger. Das Bakterium erhielt im Jahr 2022 von den kanadischen Forschenden den passenden Namen Vandammella animalimorsus – Tierbiss-Vandammella.
Die Benennung der neuen Arten ist nun auch für das Basler Team der nächste Schritt. Hierfür arbeiten sie mit Peter Vandamme von der Universität Gent zusammen, einem Spezialisten für die Klassifizierung von Bakterien. Zwei der Keime sind bereits getauft: Eines davon trägt den Namen Pseudoclavibacter triregionum – eine Referenz ans Dreiländereck.
Das Team in Basel sammelt und sequenziert nun weiterhin systematisch unbekannte Keime aus Patientenproben des Universitätsspitals – mittlerweile sind nochmals über zwanzig dazugekommen.
Die Hoffnung: Durch die technologischen Fortschritte in der Bakteriologie wird es immer einfacher, Infektionen mit seltenen Erregern richtig zu diagnostizieren und von Anfang an effektiv zu behandeln.